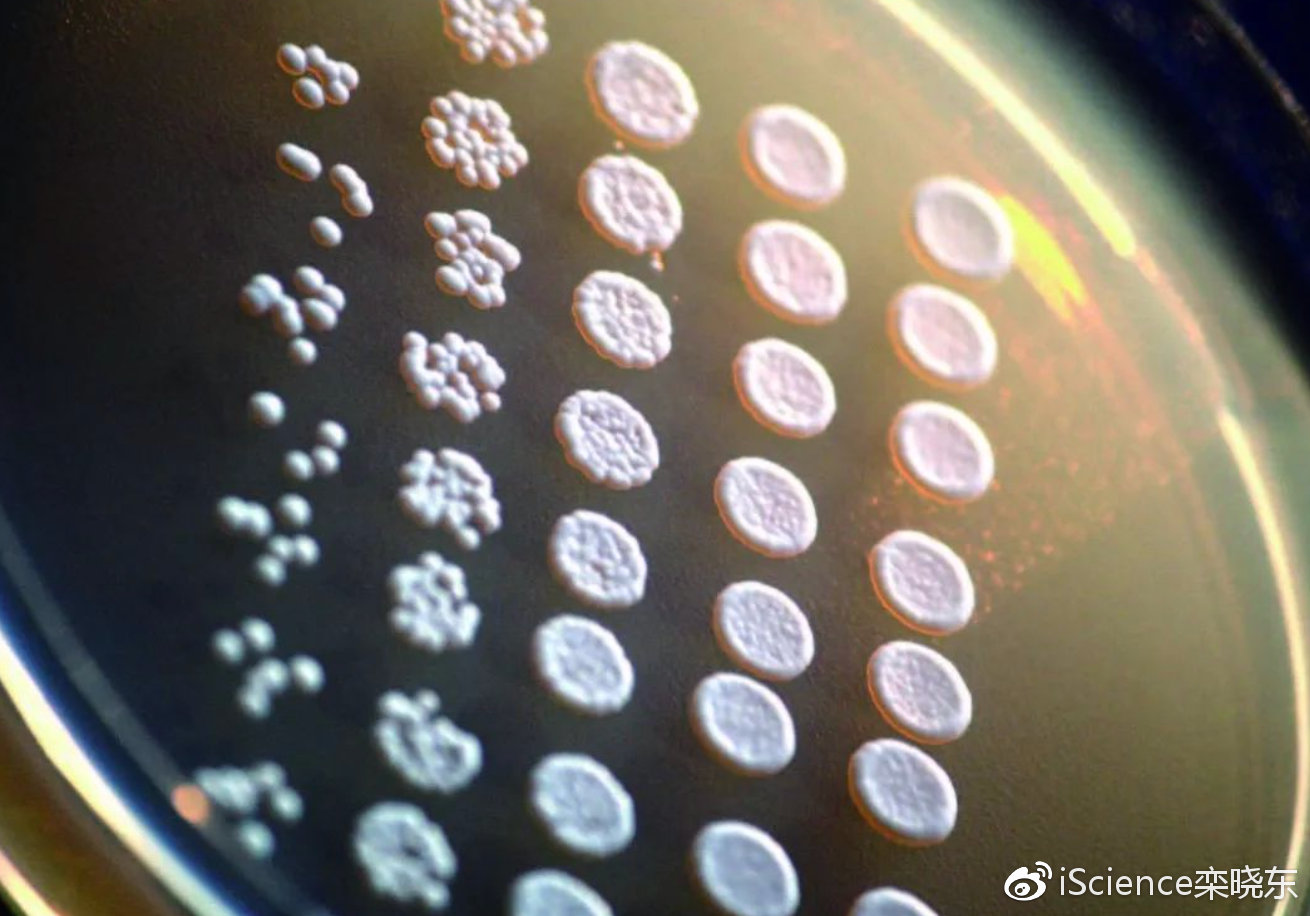
酵母蛋白的核酸含量有标准吗?

酵母核酸来源特性与提取应用
酵母核酸这东西其实就是从天然酵母里头提取出来的,含量嘛,因为酵母种类不同,大概在3%到15%之间浮动。现在的提取技术可先进了,都是用现代生物技术进行分离提纯,最后得到的成品纯度能达到85%以上,相当不错了!市面上卖的酵母核酸产品形态多种多样,有粉状的也有膏状的,含量范围从85%到95%不等。这些高纯度的酵母核酸在医药领域应用特别广泛,还有很多其他行业也在用,真是个宝贝呢!
- 国家目前虽然没有专门针对酵母蛋白嘌呤的单独法规,但它必须遵守新食品原料公告的通用要求,其中核酸限值就是针对其嘌呤特性的关键规定,这一点大家要特别注意哦。
- 酵母蛋白需要满足什么条件才能宣称与嘌呤相关?其产品必须符合核酸含量规定,并且在实际食用状态下(如冲调后)的嘌呤含量需有据可依,不能随便乱说。
- 酵母蛋白是不是通过工艺降低了嘌呤?对呀,生产中有脱核酸工艺,去除了大多数核酸,嘌呤自然就降下来了,这个工艺真的很重要!
- 酵母蛋白的核酸含量有标准吗?有的。国家规定酵母蛋白的核酸含量不能超过2%,现在很多产品已经能做到1%以下,比大豆等一些植物蛋白还低,真是太厉害了!
- 酵母蛋白的核酸含量比大豆蛋白低吗?是的,酵母蛋白的核酸含量通常比大豆分离蛋白还要低,这一点可能很多人都不知道呢。

酵母蛋白与胶原蛋白区别懂的人回谢谢
酵母蛋白是一种存在于天然酵母中的优质完全蛋白,哇塞,它的蛋白质含量可超过干重的一半,营养价值相当高!不过呢,它也有个小缺点,就是必需氨基酸组成中相对缺乏含硫氨基酸,所以它的生物价可以通过添加甲硫氨酸来提高。但是要特别注意,由于酵母蛋白中含有较高量的核酸,如果摄入过量,可能会导致尿酸血液水平升高,引起代谢紊乱,所以吃的时候要适量哦。
相比之下,胶原蛋白就完全不同啦!胶原蛋白主要来自动物结缔组织,它的氨基酸组成和酵母蛋白差别很大,功能也不一样。简单来说,酵母蛋白更注重全面营养,而胶原蛋白更关注皮肤和关节健康,这两个真是各有千秋呢!
相关问题解答
-
酵母提取物到底是什么东西?
哎呀,酵母提取物可真是个好东西!它是由酵母经过精细处理后得到的,首先要把酵母细胞壁打破,然后提取出里面超丰富的蛋白质、核酸、维生素等天然活性成分。这些小分子氨基酸含量超过30%,总蛋白超过50%,核苷酸含量也超过10%,真是太营养了!现在它被广泛应用于食品、调味品和化妆品等多个领域,在食品中可以作为增味剂或营养强化剂,在调味品里能提升食物的口感,简直是个万能小帮手呢! -
为什么酵母蛋白要控制核酸含量?
这个问题问得好!主要是因为核酸中含有嘌呤,如果摄入太多嘌呤,可能会导致尿酸升高,引起痛风等问题。所以国家特别规定了酵母蛋白的核酸含量不能超过2%,现在很多厂家通过先进工艺已经能做到1%以下,比一些植物蛋白还要低,这样吃起来就更安全放心啦!毕竟健康最重要嘛~ -
酵母蛋白适合哪些人食用?
其实酵母蛋白适合大多数人食用,特别是那些需要补充优质蛋白的人群。因为它含有丰富的必需氨基酸,营养价值很高。但是对于有痛风或者尿酸偏高的人来说,就要特别注意选择核酸含量低的产品,或者咨询医生建议。普通人的话,适量食用是完全没问题的,还能补充营养,真是一举两得! -
如何辨别优质的酵母蛋白产品?
首先要看核酸含量,优质产品的核酸含量都在1%以下;其次要看蛋白质含量,好的产品蛋白质含量都很高;还要看是否有相关的检测报告和认证。另外,选择知名品牌也很重要,毕竟大品牌的质量更有保障。记住这些 tips,保准你能选到优质的酵母蛋白产品!
发布评论